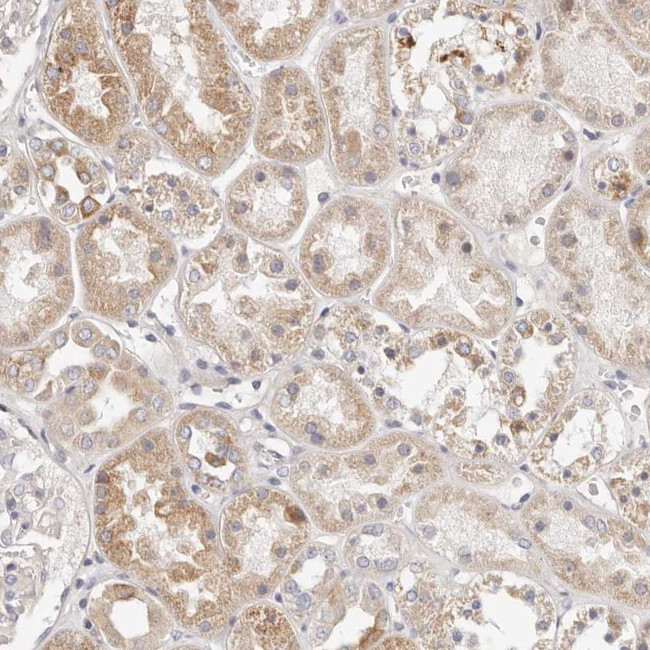
MYOM3 Antibody in Immunohistochemistry (Paraffin) (IHC (P))

Search
Invitrogen
MYOM3 Polyclonal Antibody
{{$productOrderCtrl.translations['antibody.pdp.commerceCard.promotion.promotions']}}
{{$productOrderCtrl.translations['antibody.pdp.commerceCard.promotion.viewpromo']}}
{{$productOrderCtrl.translations['antibody.pdp.commerceCard.promotion.promocode']}}: {{promo.promoCode}} {{promo.promoTitle}} {{promo.promoDescription}}. {{$productOrderCtrl.translations['antibody.pdp.commerceCard.promotion.learnmore']}}
产品信息
PA5-56246
种属反应
宿主/亚型
分类
类型
抗原
偶联物
形式
浓度
规格
纯化类型
保存液
内含物
保存条件
运输条件
RRID
产品详细信息
Immunogen sequence: CRCPIQGLVE GQSYRFRVRA ISRVGSSVPS KASELVVMGD HDAARRKTEI PFDLGNKITI STDAFEDTVT IPSPPTNVHA SEI
Highest antigen sequence identity to the following orthologs: Mouse - 77%, Rat - 78%.
靶标信息
MYOM3 (myomesin 3) is a structural component of the M-band in striated muscle and is involved in sarcomere stability and resistance during intense or sustained stretching. MYOM3 can be detected mainly in intermediate speed fibers of skeletal muscle. Recently high level of MYOM3 fragments were detected in sera from patients with muscular dystrophy, including Duchenne muscular dystrophy (DMD). MYOM3 fragments may be used as serum biomarker for DMD and other neuromuscular disorders.
仅用于科研。不用于诊断过程。未经明确授权不得转售。
篇参考文献 (0)
生物信息学
蛋白别名: Myomesin family member 3; myomesin family, member 3; Myomesin-3; unnamed protein product
基因别名: MYOM3
UniProt ID: (Human) Q5VTT5
Entrez Gene ID: (Human) 127294